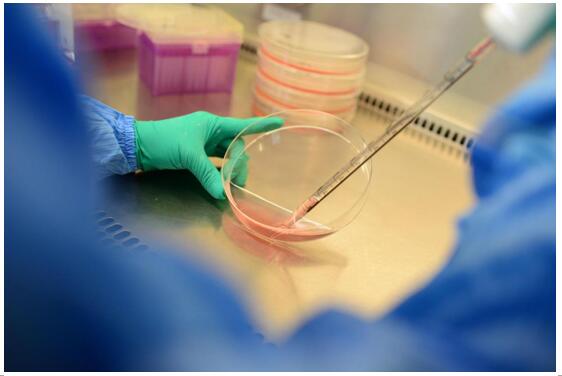

创新型胸腔积液治疗技术亮相武汉健博会 载药囊泡备受参展商关注
4月7日至10日,由武汉市政府主办、湖北省楚商联合会承办的
首届“世界大健康博览会”在武汉国际博览中心隆重举行。本次健博会以“科技引领,健康未来”为主题,吸引了来自海内外超过2000家品牌及企业参展,涵盖生物医药、医疗器械、医疗科技、健康金融等多个领域。而在此其中,湖北盛齐安生物科技股份有限公司展位前人头攒动、客商云集,如此热闹场面也正是因为其颠覆性的胸腔积液创新治疗技术让前来咨询的市民及参展商都眼前一亮、盛赞不已。

据现场盛齐安工作人员介绍,盛齐安载药囊泡治疗肿瘤技术是全球首创技术,经过近十年的研发和临床转化,目前已成功完成在中国市场的临床转化。据介绍,截止目前该技术已取得天津市、深圳市、湖北省和安徽省等四省市的新增医疗服务项目价格批示,预计4月份将率先用于恶性胸腔积液(“胸水”)的治疗。
什么是胸腔积液?恶性胸腔积液(malignantpleural effusion,MPE)也叫胸水,是指原发于胸膜的恶性肿瘤或其他部位的恶性肿瘤转移至胸膜引起的胸腔积液,该疾病会引起患者胸闷、呼吸困难等症状,同时也会降低患者生存质量,影响患者的生存周期。数据显示,大部分恶性肿瘤发展到晚期都会出现恶性胸腔积液,属于多种肿瘤的并发症之一。数据显示,MPE的发病率约为每年十万分之三十五,即每年新发病例80万人左右。一旦出现MPE,肿瘤患者的中位生存时间只有3~12个月。
截至目前,针对恶性胸腔积液的治疗已形成治疗指南,但并无治愈恶性胸腔积液的方法,现有指南大都以缓解患者症状的方式予以治疗。
2018年10月,美国胸科学会(ATS)发表了最新版MPE治疗指南,主要基于最近几年的新证据作了一些新的推荐,但是指南仍将所有注意力集中在缓解MPE患者最痛苦的症状,即呼吸困难上。在过去5年中,关于MPE的治疗性研究,包括国际权威综合医学杂志NEJM和JAMA,以及呼吸专业主流杂志如AJRCCM、Thorax、ERJ和Chest等发表的临床研究论文,均没有突破性研究进展。
直到今年1月,武汉协和医院金阳教授团队在《Science Translational Medicine》(IF:16.710)杂志上发表了载药囊泡治疗恶性胸腔积液的最新临床研究成果,其对难治性复发性恶性胸腔积液的治疗展现了良好的安全性和有效性,引起了医学界的广泛关注。
据盛齐安生物研发总监张一介绍,载药囊泡治疗肿瘤技术针对恶性胸腔积液的治疗原理是,肿瘤细胞释放的嚢泡与化疗药物有机结合后形成的载药囊泡,可靶向杀伤胸腔内肿瘤细胞和肿瘤干细胞,抑制血管内皮生长因子及炎性因子的释放,遏制胸水生成,其突出性的三大功能是靶向杀伤肿瘤干细胞、逆转耐药和低毒副作用。
所谓肿瘤干细胞,是肿瘤复发和转移的“元凶”。对比普通肿瘤细胞,肿瘤干细胞十分柔软,可摄取更多载药囊泡,载药囊泡进入肿瘤细胞后,可减少药物外排,增加药物的核转运,让更多药物进入细胞核内,更高效杀伤肿瘤干细胞,缓解胸腔积液的复发概率。

作为载药囊泡治疗肿瘤技术主要研究者之一,金阳教授对载药囊泡技术阐述了自己的看法:载药囊泡治疗肿瘤技术的用药量仅相当于传统化疗方法的几千分之一,但作用于肿瘤细胞的药量却远高于传统化疗,且疗程大幅缩短,全身的副反应和毒副作用也明显降低。这是国际创新的理论和技术,它把靶向治疗与生物化疗有机结合,是肿瘤全新的综合治疗模式,为肿瘤的长期缓解带来曙光。
截至目前,围绕这一技术,盛齐安生物已与全国30多家知名三甲医院作开展各类合作,包括中国肿瘤治疗高地中国医科院肿瘤医院、武汉协和医院、武汉同济医院、中南大学湘雅二医院、郑州大学第一附属医院等。诸多临床专家反馈,载药囊泡治疗肿瘤技术开辟了肿瘤治疗新方法,疗效和安全性显现良好,临床应用前景广阔。
张一先生在健博会后接受采访表示,盛齐安在完成了前期的准备工作后,这项具有中国自主知识产权的新技术计划于今年4月正式上市,并率先应用于恶性胸腔积液的治疗,届时将打破恶性胸腔积液临床治疗僵局。未来,载药囊泡治疗肿瘤技术还将在恶性腹水、胆管癌和肺癌等实体瘤领域逐步开展临床应用,造福更多的癌症患者。
更多内容请关注盛齐安官方网站http://www.soundnybio.com/index.html或微信公众号了解详情!
小贴士:湖北盛齐安生物科技股份有限公司成立于2009年,是一家专注于“载药囊泡治疗肿瘤技术”研发、应用与推广的高科技生物医药企业,于2017年2月正式挂牌新三板。2017年9月至今,盛齐安“载药囊泡治疗肿瘤技术”先后取得天津市、湖北省、深圳市和安徽省的新增医疗服务项目价格批示,将在恶性胸腔积液(也称“胸水”)、恶性腹水及胆管癌、肺癌等实体瘤方面开展临床应用。






